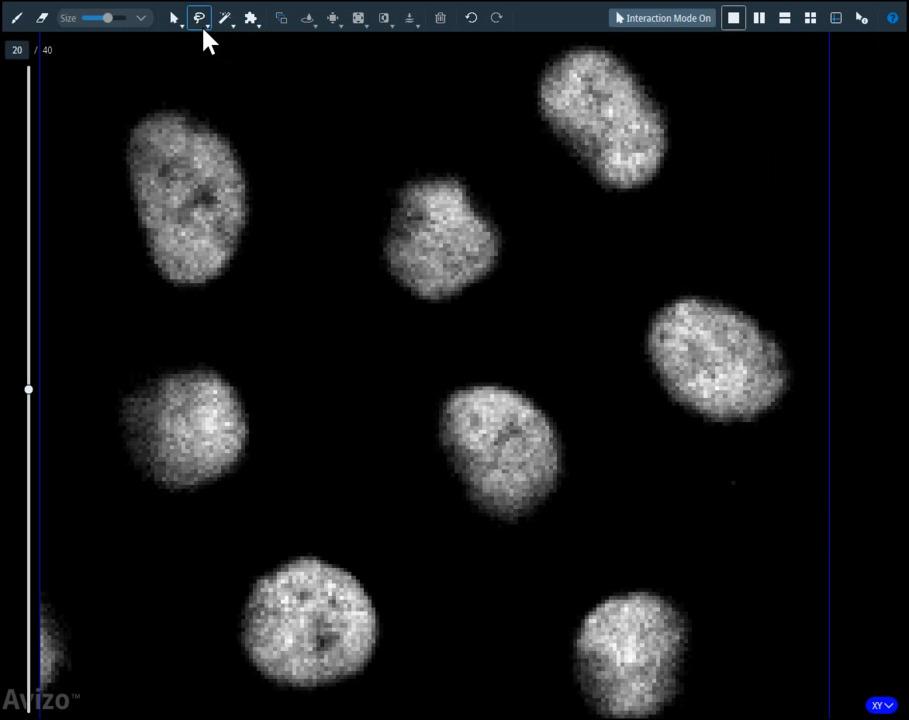

Search
Next-generation AI-powered image segmentation for complex data
Thermo Scientific Amira Software for life sciences and Avizo Software for materials science help you segment complex data with confidence. The purpose-built Segmentation+ Workroom extends these capabilities with tools designed to handle diverse data types and analysis goals.
It brings together interactive, automated, and AI-based segmentation in a single, user-friendly environment so you can customize the workroom to your workflow to reduce manual effort, improve consistency, and accelerate your analysis.
AI-assisted image annotation tool
The AI-Assisted Selection implemented in the Segmentation+ Workroom tool uses smart seed-based technology to quickly identify objects in an image with just one click. This advanced AI model speeds up the selection process in the Segmentation+ Workroom, making it easier to annotate images for training a Deep Learning model with the AI-Assisted Segmentation tool.
AI-supported image segmentation
The Segmentation+ Workroom uses innovative AI-based tools for image segmentation that make it easy to handle complex datasets. Its precise AI algorithms automatically analyze and segment images to help you enhance speed, efficiency, and segmentation quality.
Designed with user accessibility in mind, our AI-based tools eliminate the need for extensive image processing expertise. Users of varying skill levels can leverage the AI tools to segment various structures, regardless of size or shape.
Advanced algorithms recognize and segment different material textures, enhancing accuracy and versatility. Within the workroom, you'll find all the necessary tools to streamline your workflow without switching software or environments.
A deep learning model recovered the inclusions in this FIB-SEM tomography volume of polymer materials. Due to charging artifacts and low contrast, deep learning outperformed classical image processing methods.
2D and 2.5D AI model training for image segmentation
The Segmentation+ Workroom now brings 2D and 2.5D AI model training together, so you can match dimensionality to your data and your goals. Choose 2D when speed matters most, delivering fast training for straightforward segmentation tasks. Step up to 2.5D for a boost in accuracy with minimal additional training time. Navigate to the workroom to explore the new AI model features.
3D reconstruction of the Golgi apparatus and ribosomes in a Chlamydomonas cell. Data courtesy EMPIAR - 11830 image archive.
AI model training, evaluation, and management
The Segmentation + Workroom supports dedicated features to train, evaluate, and manage AI models. Built-in metrics and the AI Model Manager make it easy to assess performance, retrain, and automate workflows for consistent, large-scale data analysis.
Amira and Avizo Software include full suites for evaluating and comparing models:
- Dice, Jaccard, precision, recall, and more
- Side-by-side visual comparisons
- Organized model library with export/import capabilities.
Intuitive and automated image segmentation
The Segmentation+ Workroom user interface offers an intuitive image segmentation experience with a comprehensive set of tools. It prioritizes efficiency, enabling a focused and uninterrupted workflow.
The layout was carefully designed to logically group features, ensuring easy accessibility. The data viewer in the center of the workroom seamlessly transitions between 2D and 3D. Interactive segmentation features and selection modifier tools are conveniently located above. Automated Advanced Segmentation Tools, including AI models, are positioned on the left side for easy access, but can be undocked and repositioned as needed.
Our segmentation tools are optimized for both high and low levels of zoom, allowing for swift segmentation at low magnification and precise segmentation when zoomed in.
Segmentation+ Workroom gives powerful and intuitive tools for manual, automated, or AI-assisted segmentation.
FAQ
The Segmentation+ Workroom in Amira Software for life sciences and Avizo Software for materials science is a dedicated environment for interactive and semi-automated segmentation of image data. It allows you to create or edit a Label Image, which is an image in which each segmented object or region is stored as a distinct material. This is a crucial step for generating 3D surface models, performing volume measurements, and other quantitative analyses.
The Segmentation+ Workroom allows you to segment a wide range of scientific 3D grayscale image datasets. Scanning electron microscopy (SEM) and focused ion beam-SEM (FIB-SEM), transmission electron microscopy (TEM) and serial section TEM, cryo-electron tomography (cryo-ET, cryo-EM), and X-ray computed tomography (CT and micro-CT), as well as other modalities such as MRI and optical microscopy.
The Segmentation+ Workroom in Amira Software for life sciences and Avizo Software for materials science provides a comprehensive suite of segmentation methods, including interactive tools (brush, lasso, magic wand), semi-automatic tools (threshold, watershed, and top-hat), and advanced AI-assisted and deep learning segmentation (with a 3D Pro license). Post-processing tools like Remove Islands and Smooth Label further refine results. You can combine and script for flexible, robust segmentation workflows tailored to diverse scientific imaging applications.
Load the dataset and ensure voxel size and units are correctly set. You can improve image quality by applying image processing tools (e.g., smoothing, denoising, contrast enhancement) and for modality-specific artifacts (e.g., CT ring artifacts). You can apply correction modules as needed. For image stacks, align slices using the Align Slices module if necessary. Registration and fusion tools are available for multi-modal or multi-volume datasets.
The AI Assisted Segmentation Tool in the Segmentation+ Workroom lets you quickly segment complex images by training a neural network on minimal, user-annotated regions of interest. The tool then predicts and labels the entire dataset, with options for iterative refinement and model evaluation, all within an interactive, user-friendly workflow.
You can use pretrained models and transfer learning in the Segmentation+ Workroom by importing models, initializing training with existing weights, and applying them to new datasets. This is primarily done through the AI-Assisted Segmentation Tool and Deep Learning modules, with support for standard and custom architectures.
Yes. Amira Software's and Avizo Software's AI Model Manager lets you export and import trained models, making it easy to share them with other users or labs. This promotes reproducibility and consistency across teams, helping ensure identical analysis workflows even on different systems.
Amira Software's and Avizo Software's AI and deep learning segmentation tools, including the Segmentation+ Workroom, DL Training - Segmentation 3D Module, and Deep Learning Prediction Workflow, support 3D patch inference for large volumes. This enables efficient segmentation of datasets that exceed system memory, using patch-based processing and inference strategies.
For optimal performance when segmenting large datasets in Amira Software and Avizo Software, the following hardware specifications and recommendations should be followed: Graphics card (GPU) (highest for segmentation, visualization, and deep learning), system memory (RAM) minimum is 16 GB RAM, and for the processor (CPU), the more cores and higher clock speed, the better for image processing and parallel tasks. Hard drive storage requires 16 GB free disk space (minimum for installation).
The Segmentation+ Workroom is recommended for new workflows due to its improved performance, unlimited materials, advanced tools, and better navigation. However, it is limited to in-memory grayscale images, does not support some legacy tools, and cannot segment LDA or color images directly. Classic Segmentation Workroom is deprecated, limited in materials, and lacks advanced features, but may still be used for legacy projects until it is fully removed.
A label field in the Segmentation+ Workroom is the central data object that stores the segmented image, assigning each voxel in a 3D image to a specific material or region. It enables visualization, quantification, modeling, and export for downstream analysis in Amira Software's and Avizo Software's.
Materials are the labeled regions in your segmentation. Phases are the physical or compositional components you want to distinguish (often mapped to materials). ROIs are user-defined sub-regions of the image represented as an axis-aligned 3D box.
Related products
For Research Use Only. Not for use in diagnostic procedures.